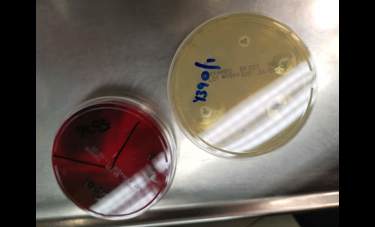
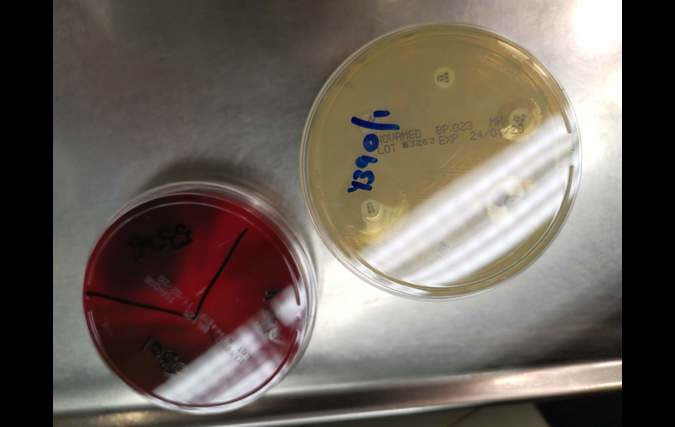
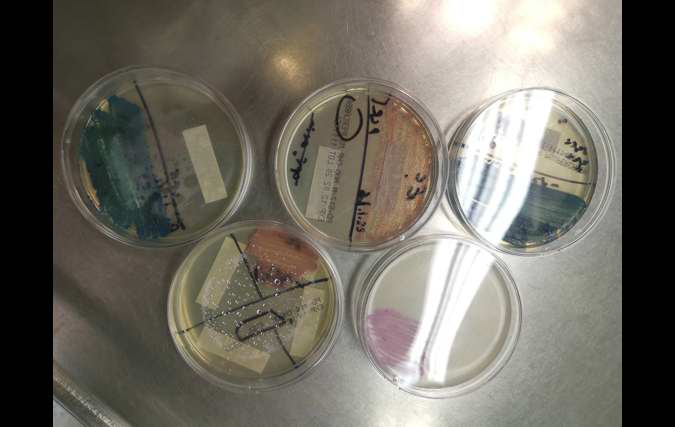
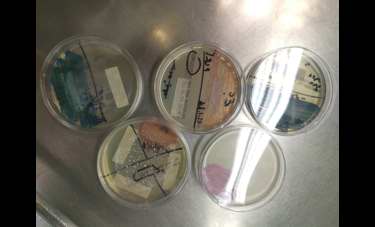

סטודנטים בשנה ב' בחוג למדעי המעבדה רפואית יצאו לסיור במעבדות למיקרוביולוגיה קלינית בבית החולים הדסה עין כרם (בניהולה של ד"ר ויולטה טמפר).
בסיור פגשו הסטודנטים את ד"ר איילת גייגו, בוגרת החוג למדעי המעבדה הרפואית במכללה ואחראית היחידה המולקולרית במעבדה. היא שיתפה את הסטודנטים בסיפורה האישי ודרכה האקדמית והמקצועית, מלבורנטית ועד לתואר שני ושלישי ואחריות על מעבדה הנותנת שרות לבית החולים הדסה ולבתי חולים רבים נוספים ברחבי הארץ, ועד עיסוקה במחקר.
בהרצאתה סיפרה ד"ר גייגו על שיטות מולקולריות מגוונות בינהן Real Time PCR ריבוטייפינג ו Multiplex PCR. הסטודנטים שמעו סיפורים קלינים מרתקים שהמחישו טת חשיבותה הרבה של המעבדה הרפואית ועובד המעבדה בהצלת חיי אדם.
הסטודנטים למדו על מגוון השיטות הרבות בהן משתמשים במעבדה למיקרוביולוגיה, משיטות זריעה ועד שיטות מתקדמות כמו MALDI TOF.
צוות המעבדה קיבל בחום את הסטודנטים ואירח אותם בשמחה לכל משך הסיור.